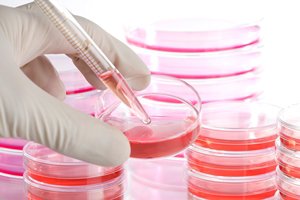

به گزارش تابناک سمنان و به نقل از باشگاه خبرنگاران، حسن رهایی رئیس جهاددانشگاهی استان سمنان با بیان اینکه ۲۴ آبان ماه معادل با ۱۵ نوامبر به عنوان روز جهانی ذخیره سازی سلول های بنیادی خون بندناف نامگذاری شده است گفت : امکان این خدمت رسانی به تمامی هم استانی ها در تمامی بیمارستان های سطح استان فراهم شده است.
وی افزود : خون بندناف خونی است که پس از تولد در بندناف و جفت باقیمانده و دور ریخته میشود، این خون غنی از سلولهای بنیادی و قادر به ساخت انواع سلولهای دیگر و ترمیم و نگهداری سلولها در هنگام جراحت است.
رئیس جهاد دانشگاهی استان سمنان اضافه کرد: هم اکنون در بانک خون بند ناف عمومی رویان ۱۵ هزار نمونه ذخیره سازی و در بانک خصوصی آن نیز ۸۵ هزار نمونه ذخیره سازی شده است که انتظار میرود تا پایان امسال به ۹۰ هزار نمونه برسد، در حال حاضر در دنیا در بانک های عمومی ۷۰۰ هزار و در بانک های خصوصی سه میلیون بند ناف ذخیره سازی شده و ۳۵هزار پیوند بندناف در دنیا صورت گرفته است.
رهایی با درخواست از خیرین استان سمنان برای فعالیت در این حوزه، عنوان کرد: درمان بیماران تالاسمی، سرطانهای خون و در مجموع بیماریهای خونی از این روش بسیار مؤثرتر از روشهای شیمی درمانی بوده اما هزینه نگهداری و انجام آزمایشها ژنتیکی آن سنگین بوده و این موضوع لزوم ورود خیران به این حوزه را نشان می دهد.
وی گفت: دانش ذخیره سازی درکشور کاملا بومی بوده و برای صدور این دانش به کشورهای عمان، لبنان، امارات، آذربایجان وعراق اقداماتی صورت گرفته است، در سال گذشته بیش از ۱۵ بیمار از منابع بانک عمومی و خصوصی خون بند ناف در مراکز پیوند مغز استخوان کشور مورد درمان قرار گرفتند.
رئیس جهاد دانشگاهی استان سمنان همچنین از انجام بررسیهای علمی برای اولین پیوند از طریق سلول های بنیادی در استان خبر داد و گفت: در صورت تطابق شاخص های لازم در خون بندناف ذخیره شده با فرد بیمار، اولین پیوند از طریق سلول های بنیادی خون بندناف در استان انجام میشود.
رهایی اضافه کرد: اولین مورد پیوند برای درمان بیماری تالاسمی ماژور از طریق سلول های بنیادی خون بندناف در استان سمنان نیز در دست بررسی است تا در صورت تطابق شاخص های لازم در خون بندناف ذخیره شده با فرد بیمار بتوان از این سلول ها برای درمان استفاده کرد.